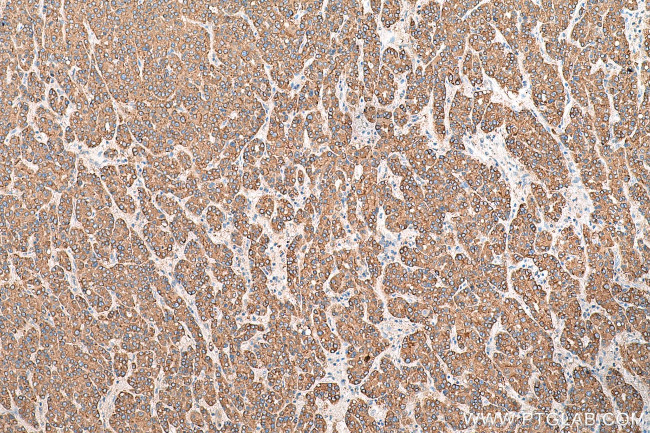
SIGMAR1 Antibody in Immunohistochemistry (Paraffin) (IHC (P))

Search
Proteintech
SIGMAR1 Polyclonal Antibody
{{$productOrderCtrl.translations['antibody.pdp.commerceCard.promotion.promotions']}}
{{$productOrderCtrl.translations['antibody.pdp.commerceCard.promotion.viewpromo']}}
{{$productOrderCtrl.translations['antibody.pdp.commerceCard.promotion.promocode']}}: {{promo.promoCode}} {{promo.promoTitle}} {{promo.promoDescription}}. {{$productOrderCtrl.translations['antibody.pdp.commerceCard.promotion.learnmore']}}











Please note: We are reviewing Western blot images included in the antibody testing data in our catalog, including those provided by third parties. Unless expressly labeled or annotated as “raw-unedited”, Western blot images included in the antibody testing data in our catalog may have been edited, optimized or otherwise adjusted for presentation.
产品信息
15168-1-AP
种属反应
已发表种属
宿主/亚型
分类
类型
抗原
偶联物
形式
浓度
规格
纯化类型
保存液
内含物
保存条件
运输条件
产品详细信息
Immunogen sequence: SEYVLLFGT ALGSRGHSGR YWAEISDTII SGTFHQWREG TTKSEVFYPG ETVVHGPGEA TAVEWGPNTW MVEYGRGVIP STLAFALADT VFSTQDFLTL FYTLRSYARG LRLELTTYLF GQDP (101-223 aa encoded by B C004899)
靶标信息
This gene encodes a receptor protein that interacts with a variety of psychotomimetic drugs, including cocaine and amphetamines. The receptor is believed to play an important role in the cellular functions of various tissues associated with the endocrine, immune, and nervous systems. As indicated by its previous name, opioid receptor sigma 1 (OPRS1), the product of this gene was erroneously thought to function as an opioid receptor; it is now thought to be a non-opioid receptor. Alternative splicing of this gene results in transcript variants encoding distinct isoforms.
仅用于科研。不用于诊断过程。未经明确授权不得转售。
生物信息学
蛋白别名: AAG8; Aging-associated gene 8 protein; AL024364; membrane protein; mSigmaR1; opioid receptor, sigma 1; OPRS1; RP23 167I12.6; SIG 1R; SIG-1R; sigma 1 receptor variant SR-1D; Sigma 1-type opioid receptor; Sigma non-opioid intracellular receptor 1; Sigma-1 Receptor; sigma1 receptor; Sigma1-receptor; sigma1R; SR BP; SR-BP; SR31747 binding protein 1; SR31747-binding protein; unnamed protein product
基因别名: AAG8; ALS16; DSMA2; HMNR2; hSigmaR1; OPRS1; SIG-1R; sigma1R; SIGMAR1; SR-BP; SR-BP1; SRBP
UniProt ID: (Rat) Q9R0C9, (Mouse) O55242
Entrez Gene ID: (Human) 10280, (Rat) 29336, (Mouse) 18391